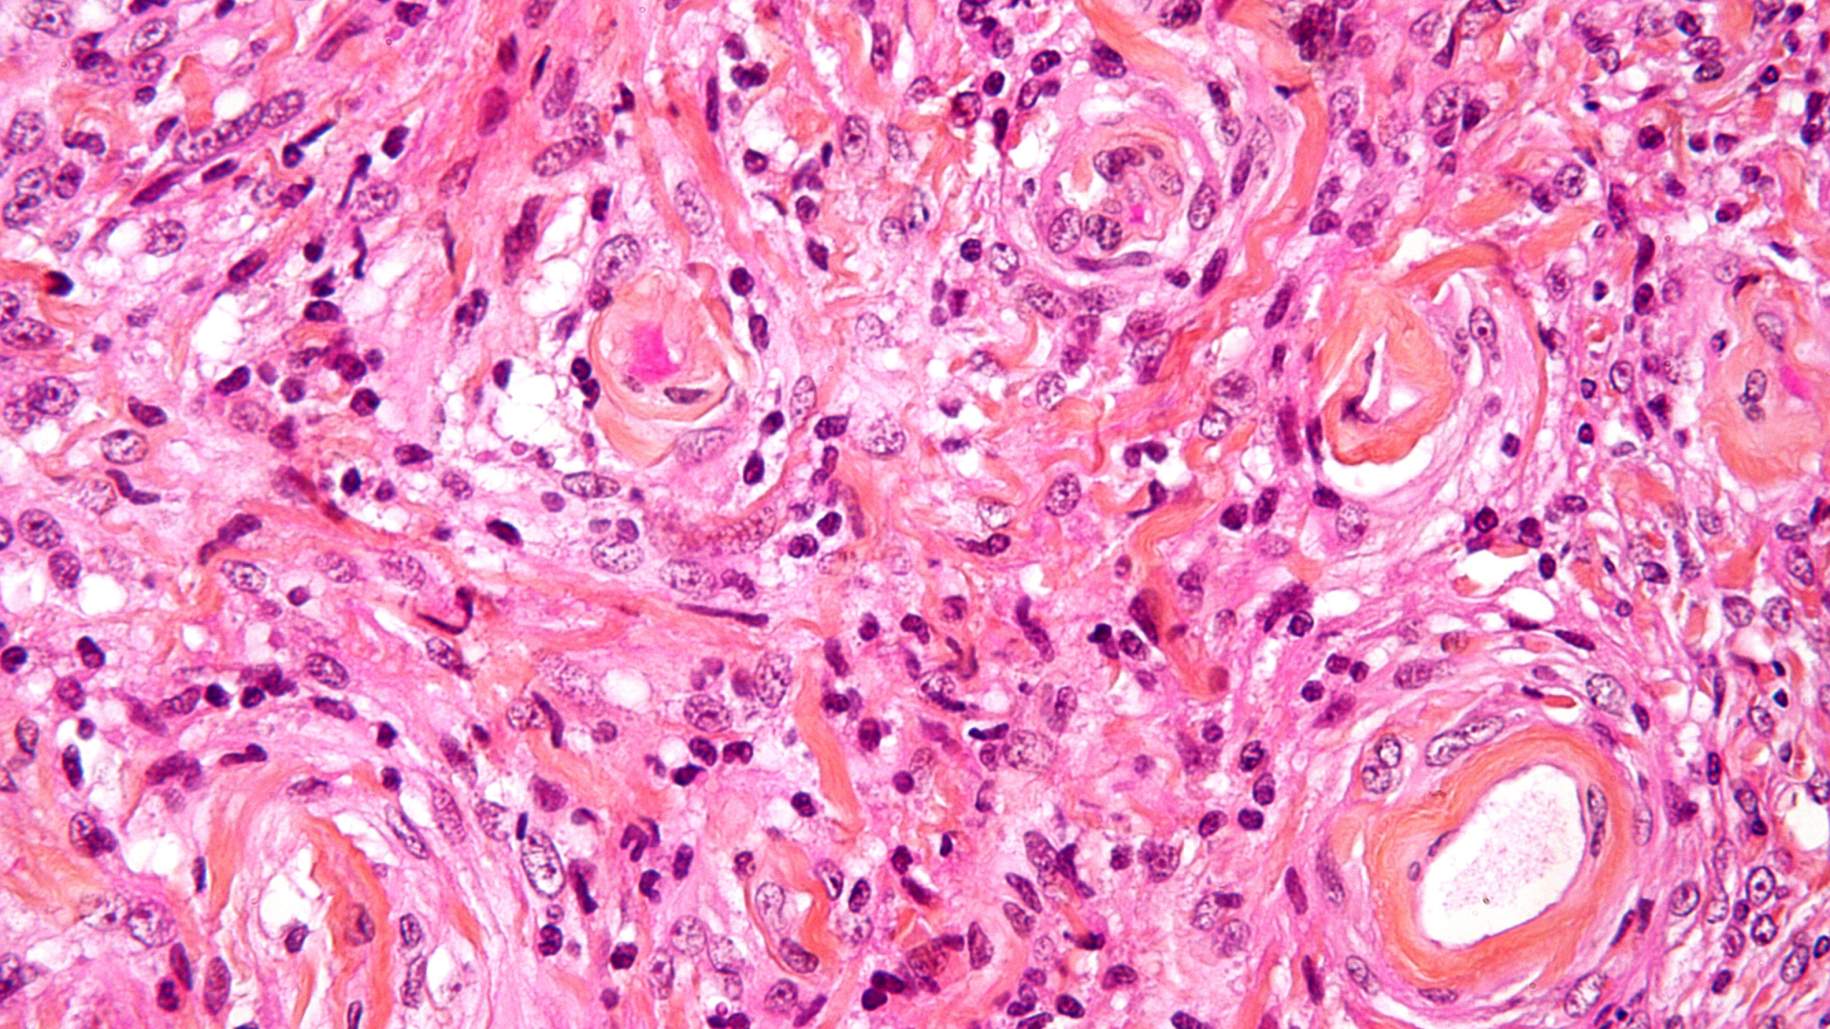

لمحة عامة عن أنواع الأورام السحائية

الأورام السحائية هي أكثر أنواع أورام الدماغ الأوّلية شيوعًا، وتنشأ من الغطاء الواقي للدماغ الذي يُطلق عليه اسم السحايا. بعد تشخيص الورم السحائي، غالبًا ما يكون لدى المرضى والقائمين على رعايتهم أسئلة حول ما هو الورم السحائي وما يعنيه هذا التشخيص لمستقبلهم.
في هذه السلسلة من المقالات، سنَصِف كيفية تصنيف الأورام السحائية بناءً على حجمها، وموقعها، وخصائصها الخلوية. بالإضافة إلى ذلك، سنناقش كيفية تأثير هذه الصفات على قرارات العلاج والتشخيص. في هذا القسم التمهيدي، نلخص هذه المقالات و نحثك على زيارة الروابط الأخرى للحصول على مزيد من المعلومات.

ما هي الأنواع المختلفة من الأورام السحائية؟
تصنف الأورام السحائية إلى أنواع مختلفة بناءً على الحجم والموقع والميزات الخلوية التي لوحظت تحت المجهر (أي درجة الورم). بعض انواع الورم السحائي لها أسماء بديهية (على سبيل المثال، "الورم السحائي الصغير" عادة ما يكون أقل من 3 سنتيمتر)، في حين أن البعض الآخر قد يتطلب معرفة أكثر تخصصًا حول علم التشريح حتى يمكن فهمها. على سبيل المثال، يتطور الورم السحائي في الأخدود الشمي بالقرب من الموقع الذي يعمل فيه العصب الشمي لتوجيه المعلومات حول الرائحة من الأنف إلى الدماغ.
حجم الورم السحائي وما إذا كان يسبب تورّماً مؤثراً في الدماغ عاملان أساسيان في اتخاذ قرار ما إذا كان العلاج ضروريًا. من المرجح أن تضغط الأورام السحائية الأكبر حجمًا على الهياكل المجاورة وتسبب أعراضًا أكثر من الأورام السحائية الأصغر. غالبًا لا تسبب الأورام السحائية الصغيرة أعراضًا، وبدلاً من ذلك يتم اكتشافها بالمصادفة عند إجراء تصوير الدماغ لسبب غير ذي صلة. في هذه الحالات، قد لا تتطلب الأورام السحائية الصغيرة وغير المصحوبة بأعراض علاجًا فوريًا لأن معظم الأورام السحائية تعتبر حميدة وليست سرطانية. تشمل انواع الورم السحائي بناءً على الحجم ما يلي:
- صغير: يبلغ قطرها عادة أقل من 3 سنتيمتر.
- كبير: قطر أكبر من 3 سنتيمتر.
- عملاق: قطره عادة أكبر من 5 سنتيمتر.
العلاجات التي يمكن تقديمها تعتمد على موقع الورم السحائي. فعلى الرغم من أن خيار العلاج الأوّلي للورم السحائي غالبًا ما يكون الجراحة، إلا أن بعض الأورام السحائية قد توجد في عمق الدماغ وتلتصق بالبنى الحساسة مما يجعل من الصعب إزالتها بأمان. في هذه الحالات، الخيارات البديلة مثل الملاحظة مع التصوير الإشعاعي بعد 6 أشهر أو العلاج الإشعاعي الذي يستهدف الورم قد يكونا الخيارين الأفضل. فيما يلي سرد لانواع الورم السحائي الشائعة بناءً على الموقع:
- مجاور للمستوى السهمي: يقع بجانب المستوى السهمي أو الخط الوسطي الذي يقسم دماغك إلى نصفين يمين ويسار.
- تحدب: تقع على الأسطح المنحنية ("المحدبة") "الجانبية" للدماغ.
- الجناح الوتدي: تقع على حافة العظم الوتدي.
- الأخدود الشمي: يقع بالقرب من الأعصاب الشمية التي تزود الدماغ بمعلومات عن الرائحة.
- فوق السرج التركي: يقع بالقرب من الأعصاب البصرية التي تنقل المعلومات عن الرؤية من العين إلى الدماغ.
- الحفرة الخلفية للمخ: يقع بالقرب من مؤخرة الرأس وأسفل الجمجمة بجوار جذع الدماغ والمخيخ.

صورة 1. تصنف الأورام السحائية وفقًا لمواقعها المعتادة.
على الرغم من أن الحجم والموقع يوفران معلومات مهمة حول إمكانية الوصول إلى الورم للجراحة، إلا أن المرضى أكثر قلقًا بشكل مفهوم حول مدى شراسة الورم وما يعنيه ذلك لبقائهم على المدى الطويل. ينعكس هذا في تصنيف منظمة الصحة العالمية (WHO) الموضح أدناه.
ما الذي يدفعك لإجراء عمليتك مع الدكتور كوهين؟
الدكتور كوهين
- أكثر من 7500 جراحة مُتخصصة قام بإجرائها بعد أن وَقع اختيارك عليه
- ستجد المزيد من الرعاية الشخصية
- خبرة واسعة = معدل نجاح أعلى وأوقات تعافٍ أسرع
المراكز الصحية الرئيسية
- لا تتحكم في اختيار الجراح الذي يعتني بك
- رعاية عامة للجميع
- التركيز على عدد قليل من التخصصات
لمزيد من الأسباب، يُرجى النقر هنا.
كيف يتم تصنيف الأورام السحائية؟
أنشأت منظمة الصحة العالمية (WHO) نظام الدرجات لوصف الخصائص الخلوية للخلايا السرطانية عند عرضها تحت المجهر. يخصص هذا النظام الأورام السحائية على أنها درجات: الأولى والثانية والثالثة، من الأقل إلى الأكثر شراسة. الأورام ذات الدرجات الأعلى تكون أكثر عدوانية وترتبط بتوقعات تعافي أسوأ.
تعتبر الأورام السحائية من الدرجة الأولى لمنظمة الصحة العالمية النوع الأقل عدوانية والأكثر شيوعًا من الأورام السحائية. تميل إلى النمو ببطء ومن غير المرجح أن تغزو الأنسجة المجاورة أو تنتشر إلى أجزاء أخرى من الدماغ. بالإضافة إلى ذلك، والأهم من ذلك، أن احتمالية تكرارها تكون أقل بعد العلاج. بسبب هذه الصفات، تعتبر الأورام السحائية من الدرجة الأولى حميدة ولديها أفضل تشخيص وتوقعات تعافي.
تعتبر الأورام السحائية من الدرجة الثالثة وفقاً لتصنيف منظمة الصحة العالمية أقل انواع الورم السحائي شيوعًا، ولكنها الأكثر عدوانية. هي الأكثر احتمالاً أن تغزو الأنسجة القريبة وأن تنتشر إلى أماكن أخرى في الجسم. بالإضافة إلى ذلك، لدى تلك الأورام أعلى احتمالية للتكرار بعد العلاج. بسبب هذه الخصائص المؤسفة، تُعتبر الأورام السحائية من الدرجة الثالثة خبيثة ولديها أسوأ توقعات تعافي. تُعتبر الأورام السحائية من الدرجة الثانية وفقاً لتصنيف منظمة الصحة العالمية غير نمطية. احتمالية انتشار تلك الأورام وتكرارها بعد العلاج تقع ما بين تصنيفي الدرجة الأولى والثالثة.
الاستنتاجات
يمكن تصنيف الأورام السحائية بناءً على حجمها وموقعها وخصائصها الخلوية. هذه الخصائص مهمة لاتخاذ قرارات العلاج والتنبؤ بفرص التعافي.
النقاط الهامة
- يُحدد حجم الورم السحائي ووجود الأعراض ما إذا كان العلاج ضروريًا. غالبًا ما تتطلب الأورام السحائية الأكبر حجمًا علاجًا بينما قد لا يتم اكتشاف الأورام الصغيرة.
- يتم تصنيف الأورام السحائية بناءً على خصائصها الخلوية. يُحدد نظام الدرجات مدى عدوانية الورم ويتنبأ بنتائج تعافي المرضى.











